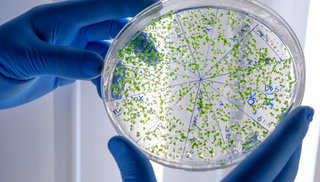

Dr. Barbara Hendel kennt Krankheit nicht nur aus Lehrbüchern.
Als junges Mädchen litt sie selbst an Neurodermitis und Asthma. Medikamente linderten Symptome – heilten aber nicht. Nach dem Absetzen verschlechterte sich alles.
Dieser Moment wurde zur Initialzündung.
Die Erkenntnis:
Es muss mehr geben als reine Symptombehandlung.
Sie studierte zunächst Betriebswirtschaft an der LMU München – auf Wunsch ihres Vaters. Doch ihr eigentlicher Traum war Medizin.
Sie absolvierte ihr Medizinstudium, wurde Ärztin – und verband zwei Welten:
medizinische Expertise und unternehmerisches Verständnis.
Eine Kombination, die heute den Qualitätsstandard von PRObiom® prägt.